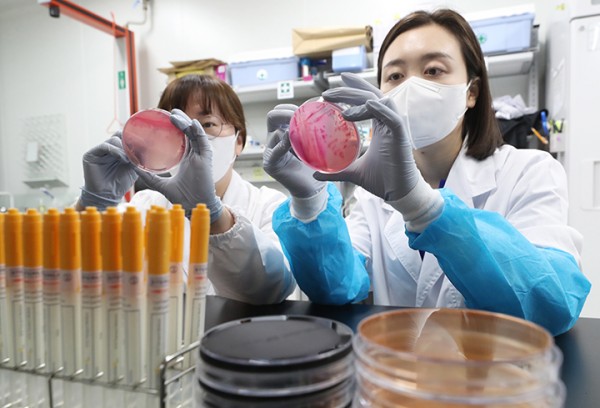
fb8c7bc30ffe1a679c9cc8d4786114c5_1752894056_404.jpg

더운 여름철 날씨에 식중독 위험성이 높아지고 있는 가운데 경기 수원시 권선구 경기도보건환경연구원에서 감염병연구부 수인성질환팀 직원이 식중독균 배양검사를 하고 있다.
식약처, 손씻기·보관온도·구분사용·가열조리·세척 및 소독 등 5대 예방수칙 실천 당부
고온·다습한 여름철에는 개인 위생관리를 소홀히 하거나 식재료 관리에 부주의할 경우 식중독균이 더욱 빠르게 증식할 수 있어 각별한 주의를 갖는 것이 필요하다.
이에 식품의약품안전처는 본격적인 여름 휴가철을 맞아 캠핑 등 야외활동 시 식중독이 발생하지 않도록 철저한 식중독 예방수칙 '손보구가세' 실천을 당부했다.
'손보구가세'는 손씻기, 보관온도, 구분사용, 가열조리, 세척·소독 등 5대 예방수칙의 앞글자로 만든 식중독 예방 실천 구호다.
먼저 야외에서 음식을 조리하기 전후, 화장실 이용 후, 달걀·고기류 등을 만진 후 또는 음식을 섭취하기 전에는 꼭 흐르는 물에 비누 등 손 세정제를 이용해 30초 이상 깨끗하게 손을 씻어야 한다.
특히 캠핑장이나 숙박시설 등에서는 식재료를 아이스박스·아이스팩 등을 사용해 차갑게 보관·운반해야 한다.
조리한 음식은 가능한 2시간 이내 섭취해야 하고, 바로 섭취가 어렵다면 아이스박스 등을 사용해 보관한다.
만약 남은 음식물을 그대로 방치할 경우 식중독균이 증식할 수 있으므로 즉시 폐기하는게 바람직하다.
아울러 소고기와 닭고기 등 생고기는 다른 식재료와 접촉해 교차 오염되지 않도록 이중 포장하거나 별도의 아이스박스에 보관하는 것이 좋다.
아이스박스가 하나만 있는 경우에는 채소·과일 등 바로 먹을 수 있는 식품은 위쪽, 고기류 등은 아래쪽에 구분 보관해 교차 오염을 방지해야 한다.
조리 시에 소고기, 닭고기, 달걀 등은 중심온도 75℃, 1분 이상 가열하고 어패류는 85℃, 1분 이상 가열해 완전히 익혀야 한다.
식수는 생수 또는 끓인 물을 마셔야 한다.
채소·과일 등을 시원하게 먹기 위해 계곡물에 담가 놓을 경우 미생물 오염 우려가 있으므로 가급적 피하고, 계곡물을 사용한 경우에는 반드시 깨끗한 수돗물로 세척한 뒤 먹는다.
칼·도마는 채소용, 고기용, 어류용 등 식재료별로 구분해 사용하고, 야외에서 구분 사용이 어려운 경우에는 '채소→고기류→어류' 순으로 사용한다.
사용한 칼과 도마는 깨끗하게 세척한 뒤 다른 식재료를 조리해야 식중독을 예방할 수 있다.
휴가지 주변 음식점을 이용할 경우 위생상태가 우수하다고 인정된 위생등급 지정업소를 이용하는 것이 바람직하다.
위생등급 지정업소는 '식품안전나라>위해·예방>위생등급제>위생등급제 지정현황' 또는 '내손안' 앱>식품업체>(카테고리)음식점 선택>식품업체검색에서 확인 가능하다.
야외에서 주문·배달 음식을 먹을 때에는 남기지 않도록 먹을 만큼만 주문하고, 배달 용기 또는 포장 등이 오염되거나 손상되지 않았는지 확인해야 한다.
해외여행에서 가열 없이 섭취하는 샐러드, 생과일주스 등을 통해 식중독이 발생하는 경우가 있어 가급적 가열해 완전히 익힌 음식을 먹는 것이 좋다.
한편 위생·검역 등의 사유로 여행지에 따라 국내에서 가져가는 식품 반입이 불가능한 경우가 있으므로 미리 확인해야 하며, 수분함량 등이 높아 쉽게 변질될 우려가 있는 식품 등은 가져가지 않는 것이 바람직하다.

식중독 예방 5가지 실천수칙 '손보구가세'
식약처는 앞으로도 일상에서 식중독 예방수칙 실천을 습관화하고 안전한 식생활을 누릴 수 있도록 유용한 정보를 제공하고 다양한 식중독 예방 활동을 추진할 계획이다.
문의 : 식품의약품안전처 식품안전정책국 식중독예방과(043-719-2107)